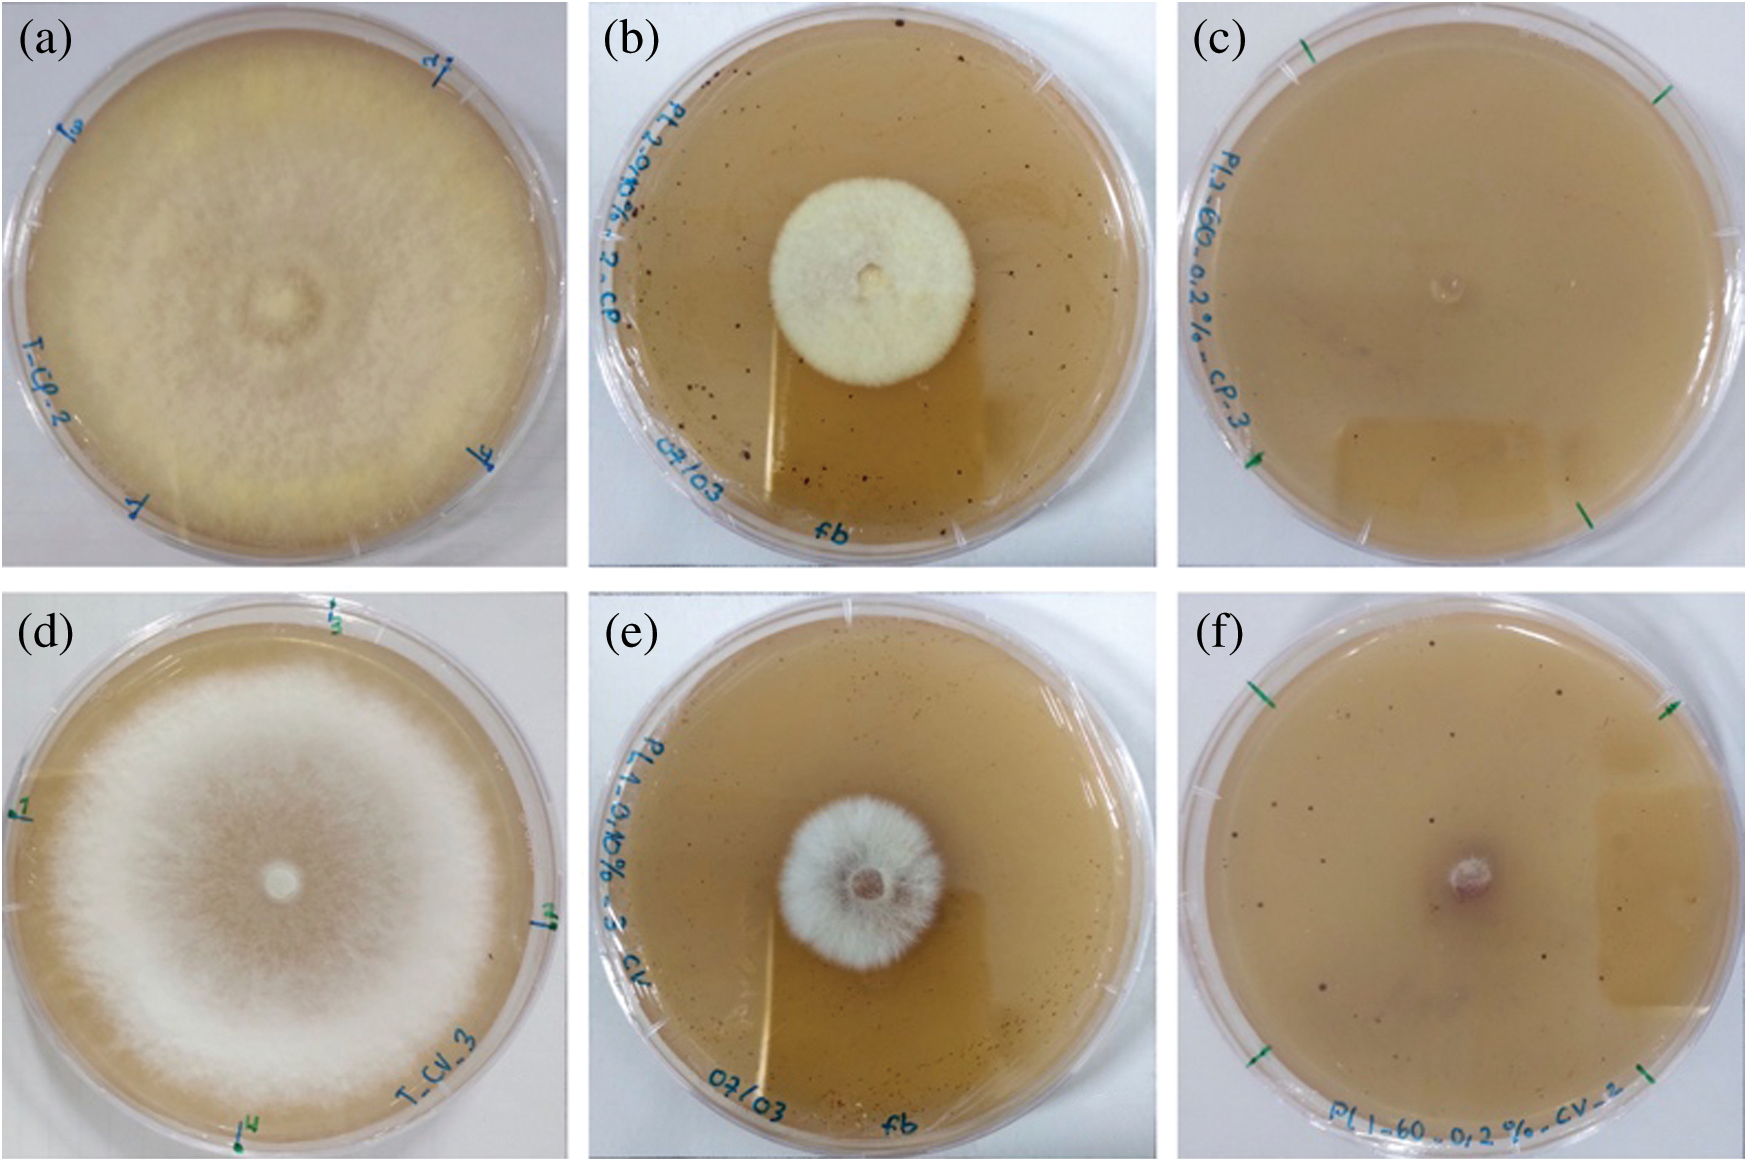
images

| Journal of Renewable Materials DOI:10.32604/jrm.2021.013147 | ![]() |
| Article |
Slow Pyrolysis of Sugarcane Bagasse for the Production of Char and the Potential of Its By-Product for Wood Protection
1CIRAD, UR BioWooEB, TA B-114/16, 73 Rue Jean-François Breton, F-34398 Montpellier, Cedex 5, France
2BioWooEB, Université de Montpellier, CIRAD, Montpellier, France
3AgroParisTech Centre de Nancy, Nancy, 54000, France
4Université de Lorraine, AgroParisTech, INRA, UMR Silva, Nancy, F-54000, France
*Corresponding Author: Marie-France Thévenon. Email: marie-france.thevenon@cirad.fr
Received: 28 July 2020; Accepted: 08 September 2020
Abstract: Sugarcane bagasse was pyrolyzed using a laboratory fixed bed reactor to produce char and its by-product (pyrolysis liquid). The pyrolysis experiments were carried out using different temperatures (400°C and 500°C), heating rate (1 °C/min and 10 °C/min), and holding time (30 min and 60 min). Char was characterized according to its thermal properties, while the pyrolysis liquid was tested for its anti-fungal and anti-termite activities. Pyrolysis temperature and heating rate had a significant influence on the char properties and the yield of char and pyrolysis liquid, where a high-quality char and high yield of pyrolysis liquid can be obtained at a temperature of 500°C and a heating rate of 10 °C/min. The yield of char and pyrolysis liquid was 28.97% and 55.46%, respectively. The principal compounds of pyrolysis liquid were water, acetic acid, glycolaldehyde, 1-hydroxy-2-propanone, methanol, formic acid, levoglucosan, furfural, followed by some phenol compounds and guaiacol derivatives. Pyrolysis liquid at a concentration of 0.20% and 0.25% (v/v) caused a 100% inhibition of Coniophora puteana and Trametes versicolor, respectively, when performing inhibition growth tests in Petri dishes. Filter paper treated with 10% of pyrolysis liquid caused 100% of termite mortality, while only 5.65%–7.03% of the treated filter papers consumed by termites at such concentration. Pyrolysis liquid is potentially effective to be used in the formulation of wood protection against fungi and termites.
Keywords: Anti-fungal; anti-termite; biomass; char; pyrolysis liquid; slow pyrolysis; sugarcane bagasse; valorization
![]() | This work is licensed under a Creative Commons Attribution 4.0 International License, which permits unrestricted use, distribution, and reproduction in any medium, provided the original work is properly cited. |
Valorization, a concept of converting the biomass or waste into more useful products, has great potential in the context of waste management, sustainable practices, and promoting the circular bio-economy system. Among other renewable resources, lignocellulosic biomass offers unique advantages, as an abundant, low-cost resource, especially for the production of fuel, energy, and source of the chemical feedstock. Presently, biomass is the only renewable material that can produce liquid fuels as an alternative to fossil fuel [1]. In many developing countries, biomass materials will contribute significantly to the development of sustainable energy sources. However, most often, direct combustion is applied when biomass is used for energy. The said method only generates low efficiency (5%–15%) [2], due to lignocellulosic biomass’s natural properties that have low density and low calorific value. The conversion of the biomass residue into the concentrated form of energy can enhance biomass utilization efficiency.
Sugarcane is one of the world’s most important crops, representing 21.1% of the total global crop production [3]. During its processing in the mill, sugarcane’s by-product, which is called bagasse, still possesses a high potential for bioenergy production. Nevertheless, being a seasonal plant, bagasse needs to be stored if it is to be utilized outside of its peak harvesting time. Also, being a hygroscopic material, bagasse is prone to moisture change during storage and subject to biodegradation [4,5]. To overcome these problems, the thermochemical conversion of bagasse can be applied by transforming it into carbon-rich char, which can subsequently be stored without any energy depletion.
Pyrolysis is a thermal decomposition of organic materials in an oxygen-deficient environment, converting the materials into solid char, condensable liquid, and non-condensable gas [6]. The relative quantity of these three fractions can be controlled by adjusting the pyrolysis parameters, such as temperature, heating rate, and solid residence time [7]. Slow pyrolysis, which occurs at a low heating rate and long vapor residence time, targets char as its main product [6,8]. The usual operational temperatures are between 400°C and 600°C, and typically yields 25–35 wt% of char and 30–50 wt% of liquid product [9]. This technique is attractive in converting the unstable biomass, such as sugarcane bagasse, which contains higher volatile matter to a stable energy-rich product. The char can also be used for electricity production or be upgraded as a high-value product such as activated carbon and soil amendments [9]. The potential of biochar for the soil application is interesting, especially when the feedstock is derived from agricultural residues as they contain minerals (ash) withdrawn from the soil. Soil amendment was reported results in a carbon-negative economy due to the retention of carbon-rich material, which is very stable once stored in soil [10,11].
The additional liquid product can also be recovered, with an interesting balance of the mass yield, yet at a modest energy yield [12]. There are various terms for the liquid product presented in the literature, including pyrolysis liquid [13], pyrolysis distillate [12,14], bio-oil [15], tar oil [16], wood vinegar [17], and pyroligneous acid [18]. The utilization of pyrolysis liquid is already of interest in many areas such as biocide, insecticide, fungicide, plant growth stimulator, and source of valuable chemicals [13,18,19]. A high concentration of acetic acid and furfural make pyrolysis liquid a potent natural pesticide [12]. Due to its large composition of bioactive chemicals, such as organic acids, phenols, ketones, aldehydes, furans, and guaiacols, pyrolysis liquid was presumed to protect the wood against fungi and termite [15]. Barbero-López et al. [14] reported that pyrolysis distillates from spruce bark, birch bark, and fiber hemp at 275°C–350°C temperatures provide inhibition to the growth of wood-decaying fungi. Pyrolysis liquid made from rubberwood and bamboo at 400°C showed better anti-fungal activity towards white-rot, brown-rot, and sapstain fungi [20]. Oramahi et al. [17] also studied the pyrolysis liquid from oil palm trunk at a 350°C as an anti-termite.
Research on the pyrolysis of sugarcane bagasse has also been previously conducted, mainly on the pyrolysis parameters and products’ characterization (biochar, bio-oil, and gas) [7,21–23]. Past studies reported that the optimum parameters to produce a high char yield were at 2°C/min–16°C/min of heating rate and at a temperature above 240°C, where significant differences of mass loss occurred at a temperature between 300°C and 500°C [7,22]. From those results, we could establish the slow pyrolysis experiments at a lower heating rate (1 °C/min and 10 °C/min) and intermediate temperature (400°C and 500°C), since the good quality of char could be obtained with higher temperatures [24].
Therefore, in this study, we aimed to evaluate the potential of sugarcane bagasse valorization via slow pyrolysis. The char resulting from different pyrolysis settings was assessed according to its yield and thermal properties, including the proximate, ultimate, and calorific analysis for evaluating its potential as an energy source. The chemical composition of pyrolysis liquids selected from the process, along with the test against the wood-decaying fungi and subterranean termite, were also investigated.
2.1 Biomass Feedstock and Preparation
The sugarcane bagasse (Saccharum spp.) was obtained from three consecutive annual harvests from la Réunion Island (French overseas territory). The bagasse has a moisture content of 8.48% and was provided as a grounded form with a particle size of <2 mm. Before the pyrolysis process, the samples were oven-dried at a temperature of 105°C for 2 h to remove their moisture content (<1%). Samples of 100 g of bagasse were used for each pyrolysis experiment.
2.2 Slow Pyrolysis Set-up and Parameters
A bench-scale fixed bed reactor equipped with a set of condensation system was used for the slow pyrolysis experiments (Fig. 1). This device was placed in a muffle furnace oven, which generates heat to the reactor. The reactor vessel has a cylinder form with a 24 cm diameter and a height of 20 cm. The reactor cap has a 59.5 cm long connecting pipe, which allows smoke to exit the oven towards the condensation system. The condenser was circulated with the ice-cooled liquid, a mixture of water and ethylene glycol contained in the cooling bath. The condenser’s temperature was held at the temperature of −15°C at the beginning of the pyrolysis experiments.

Figure 1: Experimental set-up of the pyrolysis reactor: (1) temperature control, (2) nitrogen gas supply, (3) flow control, (4) muffle furnace, (5) pyrolysis reactor, (6a and 6b) thermocouples, (7) bagasse/char, (8) condenser, (9) pyrolysis liquid, (10) cooling bath, (11) electrostatic precipitator, (12) silica gel, and (13) gas vent
The experiments were carried out at a temperature of 400°C and 500°C, a heating rate of 1°C/min and 10°C/min, and holding time of 30 min and 60 min, resulting in eight pyrolysis treatments in total. Two thermocouples were set up inside the reactor to monitor the evolution of temperature as a function of time to ensure the expected pyrolysis parameters. The constant flow of inert gas (N2) was applied at a 1 L/min rate, which removed the organic vapors and gas products from the reactor. The pyrolysis vapors were cooled down in a single-stage consisting of a double tube condenser maintained between 0°C and 5°C and an electrostatic precipitator. A bottle filled with silica gel was set up at the end of the condenser system, and the mass of the light-end compounds trapped here was used for mass balance purposes only. The yield of char and pyrolysis liquid was calculated based on the ratio between the final products’ weight to biomass’s initial weight. The pyrolysis liquid was then collected from the round flask, as illustrated in Fig. 1. The gaseous product was not recovered in this study. Each pyrolysis experiment was repeated three times.
The moisture content of bagasse [25] and char [26] were determined by heating the samples at 105°C until reaching a constant weight. For the ash content, the samples of bagasse [27] and char [26] were heated for 2 h (or until reaching stable weight) to 550°C and 710°C ± 10°C, respectively. The volatile matter of bagasse [28] and char [26] were measured by heating the samples to 900°C for 7 min. The fixed carbon was determined by difference. For the higher heating value (HHV) of biomass and char, the sample was experimentally measured using a bomb calorimeter PARR 6200 [29] and determined on its anhydrous basis (Eq. (1)).

where 4.1855 is the conversion factor (from Cal to J), m is the mass of the sample (g), Ecal is the average value of the effective heat capacity of the calorimeter as determined during calibration tests (Cal/°C), θ is the corrected temperature increase (°C), Qfuse is the energy input from the combustion of the firing wire (Cal), QN is the energy input from the formation of nitric acid (from water in the liquid state, nitrogen and oxygen in the gaseous state) (Cal), and MC is the moisture content of the sample (%).
Lastly, the elemental analysis of C, H, and N content of biomass and char was performed using an elemental analyzer VariMACROcube referred to ASTM D5373 [30] and ISO 16948 [31]. The O/C and H/C atomic ratio were then determined from the obtained weight percent and atomic weights of the corresponding elements. The ash recovery (AR) was calculated following the study conducted by Ghysels et al. [10] and determined from the ash content of bagasse (Ashbag), the ash content of char (Ashchar), and the char yield (CY) (Eq. (2)).

The energy yield (EY) and energy density (ED) were determined according to Yang et al. [32]. EY was expressed as the ratio of the heating value of char (HHVchar) and bagasse (HHVbag) multiplied by the char yield (CY) (Eq. (3)). Meanwhile, ED was determined as the ratio of energy yield and char yield (Eq. (4)).


2.4 Chemical Characterization and Water Content of Pyrolysis Liquid
Fourier transform infrared spectroscopy (FTIR) spectra of the pyrolysis liquid were recorded using a Perkin Elmer Frontier spectrometer equipped with an Attenuated Total Reflection (ATR). FTIR spectra were obtained at a nominal resolution of 4 cm–1 for 4 scans in the range of 4000–650 cm–1. The spectra were treated using RStudio using the package of MALDIquantForeign [33,34].
Gas chromatography-mass spectrometry (GC–MS) analysis of pyrolysis liquid was done using an Agilent 6890N gas chromatograph and Agilent 5975 mass spectrometer, all materials and chemicals being provided by Agilent. A 1 mL of pyrolysis liquid sample was dissolved in 10 mL of analytical grade acetone and filtered with a nylon microfilter of 0.45 mm. Afterward, 1 mL of sample volume was transferred into a glass vial followed by the introduction of internal standards (acetic-acid-d4, toluene-d8, phenol-d6, and phenanthrene-d10). The gas chromatograph was equipped with an electronically controlled split/splitless injection port and a capillary column DB-1701. The injection (1 µL) was performed at 250°C in the split mode (split = 1/10). Helium was used as carrier gas at constant flow (1.9 mL/min). GC oven temperature was programmed to hold at 45°C for 4 min, then heated to 120°C at a rate of 3 °C/min, and finally increased to 270°C at a rate of 20 °C/min. The internal standards used for the quantification were acetic-acid-d4 and toluene-d8. For the splitless mode, the injection was performed at 250°C. The oven temperature program was as follows: the initial temperature was set at 45°C for 4 min, then increased to 250°C at a rate of 3 °C/min, increased again to 270°C at a rate of 20 °C/min and held there for 60 min. Phenol-d6 and phenanthrene-d10 internal standards were used for the quantification of the compounds. The mass spectrometer was fixed at 70 eV ionization energy (ion source temperature = 230°C). Detail apparatus specification and description of the GC–MS method have been previously described by Lê Thành et al. [35]. In addition, a dilution to 1/10 (v/v) of a mixture sample in acetone was also performed to obtain the actual concentration of some calibrated compounds that were higher than the upper limit of the calibration range.
The water content of pyrolysis liquid was determined using a Karl Fisher volumetric titration (Mettler Toledo, Karl Fisher V20) following the standard test method ASTM E 203-08 [36]. The pH of pyrolysis liquid was also measured using a pH meter (Portames® 911pH). Only pyrolysis liquid produced at a temperature of 400°C and 500°C, a heating rate of 10 °C/min, and a holding time of 60 min were analyzed.
2.5 Fungal Growth Inhibition Test
Pyrolysis liquid produced at a temperature of 400°C and 500°C, a heating rate of 10°C/min, and a holding time of 60 min were tested against two types of wood-decaying fungi: Trametes versicolor (white-rot, strain CTB 863 A) and Coniophora puteana (brown-rot, strain BAM Ebw. 15). The test was carried using a malt-agar medium in a 9-cm diameter Petri-dish. The malt-agar medium was prepared by mixing 40 g of malt (Quaron) and 20 g of agar (BioMérieux) in 1 L of deionized water and sterilized using an autoclave for 20 min at 121°C. To determine the minimum inhibitory concentration (MIC), various concentrations of pyrolysis liquid (v/v) were tested (0.05%, 0.10%, 0.15%, 0.20%, and 0.25%) by diluting them directly in the malt agar solution, right after its distribution (40 mL) into a Petri-dish. The mixture was then hand-stirred immediately until homogenized and let stay until it solidified. The two types of fungi, in the form of a 0.5 cm diameter mycelium disk, were then placed centrally on the Petri-dishes, with four dishes for each type of fungi and each concentration. Afterward, the Petri-dishes were incubated at 22°C and 70% Relative Humidity (RH). The inhibition rate (Ir in %) was determined by comparing the diameter of fungal growth of the treated medium with the control (Petri-dishes contained only malt-agar medium) following the method described by Kartal et al. [16] (Eq. (5)).

where Dc is the colony diameter of mycelium from the control Petri-dishes (mm), and Dt is the colony diameter (mm) of mycelium from tested the Petri-dishes containing pyrolysis liquid.
Termites test was evaluated using the pyrolysis liquid produced at the temperature of 400°C and 500°C, a heating rate of 10 °C/min, and a holding time of 60 min. A non-choice test was conducted against Reticulitermes flavipes (ex. santonensis) termites using a Joseph filter paper (grammage 25 g/m2, Filtratech) made of pure cellulose (diameter of 4.25 cm). Pyrolysis liquid was diluted in ethanol (v/v) (Honeywell) at a 5% and 10% concentration and treated to the filter paper by immersing them for about 60 s. Two controls were also set up by soaking the filter paper in deionized water and ethanol, separately. Six replicates were tested for each treatment. All of the treated filter papers were air-dried before the test for at least 10 min or 20 min for paper treated with water.
A 9-cm diameter of Petri-dish was filled with 30 g of wet Fontainebleau sand (4 vol of sand/1 vol of deionized water). The Joseph papers were placed on the plastic mesh to avoid water saturation. The test device is illustrated in Fig. 2. Then, a total of 20 termite workers were introduced into each petri dish and put in a dark climatic chamber at 27°C and RH > 75% for 4 weeks, watered and observed regularly. The termite mortality and the loss of paper area were determined at the end of the test. A simple tool was developed to calculate paper area loss using ImageJ software and Trainable Weka Segmentation (TWS), a machine learning tool for rapidly measuring images [37].

Figure 2: The test device for termite’s evaluation using a filter paper
Multivariate regression analysis was conducted to determine each parameter’s correlation and effects on the yield values and char properties. Temperature, heating rate, and holding time was the independent parameters. We then determined the significance of each of those parameters individually using p-value and globally by seeing their R2 value.
For the anti-fungal and anti-termites test, a t-test analysis was used to compare the data from each specimen and treatment. The data were analyzed in order to see their groupings at a significance level of p < 0.05. The analysis was conducted using Microsoft Excel, R [38], and RStudio [34].
Tab. 1 summarizes the proximate, ultimate, and calorific analysis of sugarcane bagasse. The proximate analysis provides information related to the burning quality of biomass [39]. Sugarcane bagasse contains 8.5% of moisture content, 82.4% of volatile matter, 13.4% of fixed carbon, and relatively higher ash (4.2%) compared to other studies (see Tab. 1). The ash content of biomass tends to be higher when smaller particles were used [7,21]. Ash content has a detrimental effect as it is an inorganic, incombustible material, and thus can lower the burning rate. The amount of ash content depends on the nature of biomass. As an illustration, rice straw has 14% of ash content, while wood biomass such as birch wood has the lowest ash content, which is approximately 0.3% [12,32]. Sugarcane bagasse also contains a very low fuel ratio (fixed carbon/volatile matter) due to the high content of volatile matter. A fuel ratio of 1 or less is considered very low, while, as a comparison, the anthracite has a fuel ratio of 12 [40].
Table 1: Proximate and ultimate analysis of sugarcane bagasse

The ultimate analysis demonstrates the elemental composition of biomass. Sugarcane bagasse has 47.3% of carbon, 5.7% of hydrogen, 0.4% of nitrogen, and 46.7% of total oxygen and sulfur. The carbon and hydrogen contents are good criterion for power generation and contributes most to its calorific value [41]. The HHV of sugarcane bagasse was 18.1 MJ/kg. It is one of the most important energy analysis parameters, defined as the released energy per unit mass or volume from the material after the complete combustion. In contrast, the presence of oxygen decreases the fuel’s calorific value, while the low content of nitrogen and sulfur is imperative in terms of environmental aspects [42]. The analysis demonstrates that the present biomass is comparable to other sugarcane bagasse reported in different studies (Tab. 1) and possesses the potential as pyrolysis feedstock.
3.2 Effect of Pyrolysis Parameters to the Product Yields
The evolution of temperature as a function of time was monitored and corresponded well with the expected parameters. The yield of char and pyrolysis liquid is presented in Tab. 2, followed by their coefficient of regression given in Tab. 3. The temperature was observed as the most important parameter, influencing the char yield (p-value = 5.37 × 10–12) and liquid yield (p-value = 2.41 × 10–5). The two heating rates (1 °C/min and 10 °C/min) also showed a significant effect on char yield (p-value = 5.33 × 10–6) and liquid yield (p-value = 1.18 × 10–5). Meanwhile, there is no significant difference in the product yields for the holding time of 30 min and 60 min.
Table 2: Energy analysis of bagasse char and the yield of bagasse char and pyrolysis liquid

Table 3: Coefficient of regression between pyrolysis parameters and the yield of bagasse char and pyrolysis liquid based on multivariate analysis

Lower temperature promotes a higher char yield; however, it reduces the liquid yield and vice versa. The char yield was decreased from the temperature of 400°C–500°C as much as 12.65% on average. Katyal et al. [22] stated that the significant conversion of bagasse in the slow pyrolysis process occurs between 300°C and 500°C, while at the higher temperature (500°C–700°C), the decrease of char yield was considered insignificant (3%–4%). In Tab. 2, the ED of char was found higher (1.53–1.58) at higher pyrolysis temperatures, as the HHV also increases as the temperature increase. From all the conditions tested, the average of char and liquid yield varied between 28.81%–35.12%, and 49.67%–55.46%, separately. Aboulkas et al. [43] reported that pyrolysis liquid made from algal waste reaches a maximum yield at the temperature range of 500°C–550°C, while it decreases at the temperature of 600°C. At higher temperatures, the secondary reaction is likely to occur and produce a significant amount of gas.
Results showed that the heating rate of 10°C/min increased the liquid yield, but decreased the char yield. Further, Katyal et al. [22] reported that the effect of heating rate on the char yield is more noticeable at temperatures lower than 400°C. It conveys a negligible effect of the heating rate at a higher temperature when char production is the main target. The reduction of char yield at a higher heating rate has been explained as the result of the secondary cracking of the pyrolysis vapors and secondary decomposition of the char [7]. While preferring the high liquid yield, the higher heating rate should be chosen. However, at pyrolysis of 500°C, Aboulkas et al. [43] reported no significant impact on the char or liquid yield using a higher heating rate (10°C/min–50°C/min). In our study, the highest liquid yield was observed at a temperature of 500°C and a heating rate of 10°C/min (55.46%).
The decomposition of biomass during pyrolysis is associated with cellulose, hemicellulose, and lignin content. Varma and Mondal [39] reported that sugarcane bagasse comprises 47.6% of cellulose, 39% of hemicellulose, and a considerable low content of lignin (11.2%). According to Morais et al. [44], who investigated the thermal behavior of sugarcane bagasse, there are at least three critical stages in this process: (1) Dehydration, (2) Degradation of hemicellulose and cellulose, and (3) Lignin decomposition. They investigated the maximum loss rate of hemicellulose was observed at 250°C, cellulose at 330°C, and lignin between 190°C and 500°C, with the maximum mass loss rate occurs at 430°C. Hemicellulose and amorphous part of cellulose principally yield the condensable volatiles, whereas cellulose and lignin’s degradation produces gases, tar, and char [22].
3.3 Effect of Pyrolysis Parameters to the Bagasse Char Properties
The proximate and ultimate analysis of bagasse char from different pyrolysis conditions is presented in Tab. 4, followed by their coefficient of regression illustrated in Tab. 5. Temperature and heating rate were found to significantly influence the content of volatile, ash, fixed carbon, elemental carbon, and HHV, while holding time contributes to the volatile matter content only. After being pyrolyzed, bagasse char has a volatile matter of 24.31%–25.80% at 400°C, and 13.01%–16.43% at 500°C. Previous studies confirmed that the volatile matter is affected by the pyrolysis temperature [22,45], as the decrease of volatile matter follows the increase of temperature. The reduction of volatile content between the two temperatures occurs due to the cellulose and lignin decomposition. As the volatile released, fixed carbon and ash content percentage increased. The highest fixed carbon was observed at 68.50%–73.01%, while the ash content was found to be higher than 10%. The ash content in the present study varied from 10.79%–15.50%; however, it is still lower than the study conducted by Varma and Mondal [39], who found it to be 16.25%. High ash recoveries presented in Tab. 4 also showed that ash is retained within the char and attractive for its application as soil amendments [10]. Higher temperature and lower heating rate also favor the higher carbon content and higher HHV. At 500°C, lower heating resulted in higher carbon content (73.53%–75.70%) than those obtained at the higher heating rate (71.95%–72.90%). HHV produced from the sugarcane bagasse pyrolysis also increases from 18.14 MJ/kg to 28.67 MJ/kg at the higher temperature and lower heating rate. The char has a higher carbon content and a lower oxygen content compared to its raw material. The O/C and H/C molar ratio of char were lower than sugarcane bagasse due to the loss of H and O during pyrolysis. The O/C and H/C molar ratio of sugarcane bagasse was found as 0.74 and 1.43, respectively.
Table 4: Proximate and ultimate analysis of bagasse char at different pyrolysis conditions

Table 5: Coefficient of regression between pyrolysis parameters and the quality of char based on multivariate analysis

For energy application, low volatile content, low ash content, high fixed carbon, high carbon content, high H/C, low O/C, and high HHV should be preferred. Meanwhile, high ash recovery and high stable carbon contents (from fixed carbon) can be a good indicator of soil amendments. Generally speaking, bagasse char obtained at 500°C, and a heating rate of 1 °C/min or 10 °C/min has met all the criteria. Indeed, a lower heating rate promotes higher char yield and higher HHV. However, in the present study, the HHV of char from the pyrolysis of 500°C and the heating rate of 10 °C/min (27.85 MJ/kg) is already higher or comparable to the HHV of char produced on the same temperature and heating rate <10 °C/min by other studies [7,46]. Carrier et al. [7] found that the optimum HHV of bagasse slow pyrolysis (27.67 MJ/kg) was obtained at T > 450°C and a heating rate lower than 8 °C/min. As a heating rate of 10 °C/min also promotes higher pyrolysis liquid yield, it is reasonable to choose a higher temperature and higher heating rate in this study to co-produce the bagasse char and bagasse pyrolysis liquid. Since the temperature was found as a dominant factor influencing the char properties, char yield, and liquid yield, we evaluated the two types of pyrolysis liquid produced as a candidate for anti-fungal and anti-termite agents.
3.4 Characterization of Pyrolysis Liquid
Pyrolysis liquid was obtained in a dark brown color with a pungent, smoky odor. Previously, Demirbas [47] has stated that the pyrolysis liquid consisted of two distinct parts: an aqueous phase consisting of a mixture of light oxygenates; and tar, a non-aqueous phase containing insoluble organics of high molecular weight. At the time of experiment, the liquid obtained was not entirely in a separated phase (the soluble tar was presented and mixed with the aqueous phase). The heavy tar was presented, and it can be separated from the aqueous phase by the decantation [12]. However, not all the heavy tar was successfully recovered at the end of pyrolysis experiments. Some of them were trapped in the condensation system; however, this amount is not significant (~1%). To avoid the ambiguity, the term of pyrolysis liquid used in this study represents the total condensed liquid obtained from the pyrolysis experiments (crude pyrolysis liquid).
Fig. 3 demonstrated the FTIR spectra, which represents the functional group of the pyrolysis liquid. According to the spectra obtained, pyrolysis liquid was confirmed to have various chemical components, including oxygenated compounds, such as carboxylic acids, alcohols, phenols, aldehydes and ketones, and other chemical components such as alkanes, alkenes, and aromatics. The spectra of pyrolysis liquid obtained from the slow pyrolysis at the temperature of 400°C and 500°C were similar. The peak between 3400 cm–1 and 3200 cm–1 presents the O–H stretching vibration corresponding to alcohols and phenols’ content. The weak peaks observed between 3000 cm–1 and 2800 cm–1 (C–H stretching) imply the presence of alkanes. The C=O stretching vibrations between 1780 cm–1 and 1650 cm–1 indicate the presence of ketones, aldehydes, and carboxylic acids [48,49]. Peaks at 1513 cm–1 (C=C stretching vibration) correspond to the presence of alkenes and aromatics. Peaks at around 1365 cm–1 signify the presence of alkane due to the C–H vibrations [50]. The region between 1300 cm–1 and 900 cm–1 (C–O stretching and O–H deformation vibration) was reported to correspond to the presence of alcohols, carboxylic acids, ethers, esters, and phenols, while for the region between 900 cm–1 and 700 cm–1 (C–H bending) corresponds to the existence of aromatic compounds [39]. The spectra obtained were in accordance with the study carried out by Varma and Mondal [39].

Figure 3: FTIR spectra of pyrolysis liquid (PL) at the temperature of 400°C and 500°C
The main organic compounds present in the organic fraction of pyrolysis liquid are given in Tab. 6. Chemical analysis using a GC–MS allowed the quantification of 56 chemical compounds, where the total organic contents quantified were 29.63% and 25.63% for pyrolysis liquid produced at 400°C and 500°C, respectively. Indeed, the pyrolysis liquid contained some non-volatile compounds that are not GC-eluted, in which the non-quantified fraction represented 28%–32% of the liquid products. The said compounds are not determined in this study.
Table 6: Main organic compound (%) presented in the organic fraction of pyrolysis liquid

The chemical composition of the pyrolysis liquid is influenced by the content of cellulose, hemicellulose, and lignin in biomass. The holocellulose generated furans and carbohydrates, whereas the lignin led to the formation of phenolic compounds [47]. According to the analysis, pyrolysis liquid consisted of carboxylic acids, alcohols, aldehydes, ketones, furans, and anhydrosugars, whereas the acetic acid, glycolaldehyde, 1-hydroxy-2-propanone, methanol, formic acid, and levoglucosan were the principal compounds. Excluding the water, acetic acid was the significant compound composing the pyrolysis liquid, presenting 7.22%–8.48% of the liquid. Sugarcane bagasse is reported to be high in the content of xylose (15.5%–28.9%) [51], which contribute to the formation of acetic acid by the elimination of acetyl groups from the xylose unit [15,47]. Demirbas et al. [47] studied the mechanism of the pyrolysis reaction of biomass. For example, methanol resulted from the methoxyl groups of uronic acid, whereas furfural came from the xylose dehydration. Additionally, the degradation of xylan produced water, methanol, 1-hydroxy-2-propanone,1-hydroxy-2-butanone, 2-furfuraldehyde, acetic, propionic, and formic acid.
There is only a slight variation of the chemical compounds of pyrolysis liquid produced at the temperature 400°C and 500°C. However, higher organic content was found for the pyrolysis liquid produced at 400°C, which also possessed a higher content of furfural (1.19%). An increase in pyrolysis temperature contributed to the increase of phenolic compounds and decrease to the organic acid content [52]. Further, no polycyclic aromatic hydrocarbon compounds (PAHs) were found, or they were insignificant (less than 1 ppm). The PAHs content must be taken carefully into account because of their toxicity towards the environment and human health [53]. In contrast to creosote, pyrolysis liquid presented in this study could be considered to be more environmentally advantageous. According to the European standard EN 13991 [54], the maximum content of benzo(a)pyrene in creosote class B is 50 mg/kg. Cordella et al. [55] stated that PAHs are formed with a higher proportion at a higher temperature (650°C, 100°C/min). Additionally, the formation of phenol increases as the continuous secondary degradation occurs with the rising of temperature [47].
Pyrolysis liquid has 42.34 ± 0.24% and 42.30 ± 0.14% of water content at 400°C and 500°C temperatures, respectively. Temiz et al. [15] reported that bio-oil made from giant cane has a water content of 34%. Variation of water content is affected by the moisture content of biomass and dehydration reaction during pyrolysis. In addition, the condenser temperature, which is maintained at 0°C during the pyrolysis process also likely to contribute to the high levels of water, acids, alcohol, and ketones [56]. The pH was recorded at 2, in which the acidic characteristic was due to the presence of the organic acid, aldehydes, and phenols [39].
3.5 Effect of Pyrolysis Liquid in Inhibiting Fungi
Two types of pyrolysis liquid were revealed their efficacity to inhibit the growth of C. puteana and T. versicolor (Tab. 7). Fig. 4 showed the comparison of the fungal growth between the treated and untreated samples. Pyrolysis liquid produced at a temperature of 400°C slightly tends to be more active, delaying the fungal growth at low concentration, likely because of the relatively higher organic materials content. According to the GC-MS analysis, pyrolysis liquid at 400°C contains higher organic acid and furfural than the pyrolysis liquid obtained at 500°C. At a 0.15% concentration, pyrolysis liquid at 400°C caused a 100% inhibition of C. puteana. Also, to inhibit the fungal growth completely, pyrolysis liquid at a concentration of 0.20% and 0.25% was required to suppress the growth of C. puteana and T. versicolor, respectively. The different effect of pyrolysis liquid towards the fungi was likely correlated to the different metabolic rates or the enzyme released by the fungi [14].
Figure 4: Growth of C. puteana (a = control; b = pyrolysis liquid at 0.10% concentration; c = pyrolysis liquid at 0.20% concentration) and T. versicolor (a = control; b = pyrolysis liquid at 0.10% concentration; c = pyrolysis liquid at 0.20% concentration)
Table 7: The percentage of inhibition of the pyrolysis liquid to the growth of Coniophora puteana and Trametes versicolor

It is difficult to compare the results with other studies since the high variability of pyrolysis liquid influenced by pyrolysis parameters and the nature of biomass used. However, mostly, at a concentration of less than 1%, pyrolysis liquid has an excellent inhibition activity against various types of wood-decaying fungi. Barbero-López et al. [14] found that the MIC values for the complete inhibition were between 0.5% and 1% by using the liquid product from the pyrolysis of tree bark and fiber hemp at the temperature of 275°C–350°C. Meanwhile, Kartal et al. [16] reported the tar oil made from the slow pyrolysis of macadamia nut shells effectively inhibited the brown-rot fungi, white-rot, and sap-staining fungi tested at the concentration of 0.20%.
The anti-fungal activity of pyrolysis liquid was likely the result of the synergetic effect from the various chemical compounds. The inhibition can also occur probably because of the compounds affect the enzymatic activity of the fungi. Several authors have reported that propionic acid [14], acetic acid [17], and furfural [12,18] exhibited anti-fungal activity. Barbero-López et al. [14] reported that at the concentration of 0.1% or below, propionic acid alone could completely inhibit fungal growth such as C. puteana. Guaiacols derivatives, which were also found in this study, such as phenol-2-methyl, phenol-3-methyl, phenol-4-methyl, phenol-2-methoxy-4-methyl, and phenol-4-ethyl-2-methoxy were also responsible for the ability of pyrolysis liquid to inhibit fungi [57,58].
3.6 Effect of Pyrolysis Liquid in Termite’s Non-Choice Test
The effect of pyrolysis liquid on the paper area loss and mortality of R. flavipes are presented in Tab. 8. Control paper samples treated with deionized water and ethanol represent the equal portion of paper area loss (76.22% and 79.3%, respectively) with a low rate of mortality (8.33%). Meanwhile, paper treated with ethanol was proved not to affect the termites feeding activity. Fig. 5 showed the remaining area of paper consumed by termites. At a 5% concentration, termites consumed less portion of the paper (18.01%–28.15%), with a small number of termites survived during a 4-week test. Statistically, pyrolysis liquid obtained at 400°C is more effective when applied at a 5% concentration. However, using a 10% concentration, both pyrolysis liquids caused complete mortality, even if, in this non-choice test, termites still consumed a little portion of the paper (5.56%–7.03%). A higher rate of termite’s mortality showed the toxic effect of pyrolysis liquid.

Figure 5: Paper consumed by termites (a = control (water); b = control (ethanol); c = pyrolysis liquid at 5% of concentration and d = pyrolysis liquid at 10% of concentration)
Table 8: Percentage of paper area loss and mortality of termites

When termites were subjected to the treated paper on the first day of experimentation, termites seemed to stay away from the treated samples, probably because of the unpleasant odor from the pyrolysis liquid. It has been known that pyrolysis liquid has a smoky flavor characteristic due to the presence of ketones, phenol, guaiacol, and syringol [19,59]. The volatile compounds released during the experimentation was believed to repel the termites as reported by Oramahi et al. [60]. However, since the results showed that some termites have to consume the treated paper to die, the repellency is not enough, and the ingestion is necessary to make the termite die. Pyrolysis liquid produced from the biomass pyrolysis has been reported to have activity against R. speratus, Coptotermes formosanus, C. curvignathus, and Odontotermes sp [61]. The presence of formaldehyde in the pyrolysis liquid, akin to that of carbamate, can affect insects’ nervous system [62]. Acetic acid and phenols also contribute to the termiticidal activity. Yatagai et al. [63] stated that formic acid showed strong termiticidal activities against R. speratus.
3.7 The Potential of Pyrolysis Liquid for Wood Protection
Pyrolysis liquid obtained from the slow pyrolysis of sugarcane bagasse was proven to be effective against fungi and termites. The effectiveness of pyrolysis liquid was believed to be the result of the synergetic action of its various chemicals, notably organic acid and phenolic compounds. The crude pyrolysis liquid obtained from this study has already provided good performances against fungi and termites, suggesting that the fractionation of the specific compound might be unnecessary, in accordance with the study by Mohan et al. [57]. Its potential utilization for wood protection has also already attracted some researchers [15,16] to conducts various studies. For instance, Lourençon et al. [64] reported that bio-oil from fast pyrolysis of residual eucalypt wood fines was an efficient anti-fungal and hydrophobic agent for wood. Barbero-López et al. [14] also reported, typically, the liquid products from slow pyrolysis show higher fungal activity than torrefaction-produced liquid. This is understandable because torrefaction, as a low-temperature pyrolysis process (between 225°C and 300°C), usually produces a liquid with lower organic compounds, mainly organic acid and water.
Indeed, current issues related to the environmental concerns and governmental regulation in banning toxic compounds of the wood preservatives led to the various efforts to search for alternatives. Different types of material such as essential oils [65–68], tannin [69,70], or improving the wood properties and durability through wood chemical modification and heat treatment process [71–73] were becoming important subjects in the wood protection field. For the liquid product from the slow pyrolysis, the potential is attractive because it encourages the valorization of the biomass waste and the liquid as the by-product. It is also worth noting that, in most cases, the organic vapors would often just be passed as waste and considered insignificant when the primary objective is producing char [74]. Further, for wood application, fixation using the minimum product through formulation should be carried out for extended efficacy through life and minimize the impacts on human health and the environment.
Slow pyrolysis is an attractive method for converting the unstable biomass, such as sugarcane bagasse, which contains high volatile matter to a stable energy-rich product, even with limited yield but results in the favorable calorific value improvement. In this study, apart from its utilization for fuel due to the high carbon content (70.50%) and HHV (27.85 MJ/kg), bagasse char is also potential to be used as soil amendments, as it has a high ash recovery (up to 98%). Additionally, the recovery of liquid products results in high mass yield, which can be optimized for its potential for wood preservatives. Bagasse pyrolysis liquid contains various chemicals, such as acetic acid, formic acid, propionic acid, phenols, and guaiacol derivatives, exhibiting the anti-fungal and anti-termite properties. At low concentration (0.25%), pyrolysis liquid was able to inhibit the growth of C. puteana and T. versicolor and was effective against R. flavipes at a concentration of 10%. Due to its efficacity against fungi and termites, pyrolysis liquid is potentially interesting for the formulation of wood protection systems. Further study is worth carrying out, particularly in investigating the behavior of pyrolysis liquid once it is integrated into the wood given the nature of pyrolysis liquid that is acidic and has a high vapor pressure in the ambient temperature.
Acknowledgement: The authors gratefully acknowledge the Indonesia Endowment Fund for Education (LPDP), Ministry of Finance, Republic of Indonesia, for the doctoral scholarship. The authors would like to express their gratitude and appreciation to Luc Pignolet from CIRAD for his technical support.
Funding Statement: The first author received the doctoral scholarship awarded by the Indonesia Endowment Fund for Education (LPDP), Ministry of Finance, Republic of Indonesia.
Conflicts of Interest: The authors declare that they have no conflicts of interest to report regarding the present study.
1. Guo, M., Song, W., Buhain, J. (2015). Bioenergy and biofuels: History, status, and perspective. Renewable and Sustainable Energy Reviews, 42, 712–725. DOI 10.1016/j.rser.2014.10.013. [Google Scholar] [CrossRef]
2. Kuang, Y., Zhang, Y., Zhou, B., Li, C., Cao, Y. et al. (2016). A review of renewable energy utilization in islands. Renewable and Sustainable Energy Reviews, 59, 504–513. DOI 10.1016/j.rser.2016.01.014. [Google Scholar] [CrossRef]
3. Figueroa-Rodríguez, K. A., Hernández-Rosas, F., Figueroa-Sandoval, B., Velasco-Velasco, J., Aguilar Rivera, N. (2019). What has been the focus of sugarcane research? A bibliometric overview. International Journal of Environmental Research and Public Health, 16(18), 3326. DOI 10.3390/ijerph16183326. [Google Scholar] [CrossRef]
4. Breccia, J. D., Bettucci, L., Piaggio, M., Siñeriz, F. (1997). Degradation of sugar cane bagasse by several white-rot fungi. Acta Biotechnologica, 17(2), 177–184. DOI 10.1002/abio.370170208. [Google Scholar] [CrossRef]
5. Dong, X. Q., Yang, J. S., Zhu, N., Wang, E. T., Yuan, H. L. (2013). Sugarcane bagasse degradation and characterization of three white-rot fungi. Bioresource Technology, 131, 443–451. DOI 10.1016/j.biortech.2012.12.182. [Google Scholar] [CrossRef]
6. Mohan, D., Pittman, C. U., Steele, P. H. (2006). Pyrolysis of wood/biomass for bio-oil: A critical review. Energy & Fuels, 20(3), 848–889. DOI 10.1021/ef0502397. [Google Scholar] [CrossRef]
7. Carrier, M., Hugo, T., Gorgens, J., Knoetze, H. (2011). Comparison of slow and vacuum pyrolysis of sugar cane bagasse. Journal of Analytical and Applied Pyrolysis, 90(1), 18–26. DOI 10.1016/j.jaap.2010.10.001. [Google Scholar] [CrossRef]
8. Bridgwater, A. V. (2003). Renewable fuels and chemicals by thermal processing of biomass. Chemical Engineering Journal, 91(2–3), 87–102. DOI 10.1016/S1385-8947(02)00142-0. [Google Scholar] [CrossRef]
9. Pecha, B., Garcia-Perez, M. (2015). Pyrolysis of lignocellulosic biomass: Oil, char, and gas. Bioenergy—biomass to biofuels. New York: Academic Press. [Google Scholar]
10. Ghysels, S., Ronsse, F., Dickinson, D., Prins, W. (2019). Production and characterization of slow pyrolysis biochar from lignin-rich digested stillage from lignocellulosic ethanol production. Biomass and Bioenergy, 122, 349–360. DOI 10.1016/j.biombioe.2019.01.040. [Google Scholar] [CrossRef]
11. Vanholme, B., Desmet, T., Ronsse, F., Rabaey, K., Van Breusegem, F. et al. (2013). Towards a carbon-negative sustainable bio-based economy. Frontiers in Plant Science, 4, 174. DOI 10.3389/fpls.2013.00174. [Google Scholar] [CrossRef]
12. Fagernäs, L., Kuoppala, E., Tiilikkala, K., Oasmaa, A. (2012). Chemical composition of birch wood slow pyrolysis products. Energy & Fuels, 26(2), 1275–1283. DOI 10.1021/ef2018836. [Google Scholar] [CrossRef]
13. Tiilikkala, K., Fagernäs, L., Tiilikkala, J. (2010). History and use of wood pyrolysis liquids as biocide and plant protection product. Open Agriculture Journal, 4(1), 111–118. DOI 10.2174/1874331501004010111. [Google Scholar] [CrossRef]
14. Barbero-López, A., Chibily, S., Tomppo, L., Salami, A., Ancin-Murguzur, F. J. et al. (2019). Pyrolysis distillates from tree bark and fibre hemp inhibit the growth of wood-decaying fungi. Industrial Crops and Products, 129, 604–610. DOI 10.1016/j.indcrop.2018.12.049. [Google Scholar] [CrossRef]
15. Temiz, A., Akbas, S., Panov, D., Terziev, N., Alma, M. H. et al. (2013). Chemical composition and efficiency of bio-oil obtained from giant cane (Arundo donax L.) as a wood preservative. BioResources, 8(2), 2084–2098. DOI 10.15376/biores.8.2.2084-2098. [Google Scholar] [CrossRef]
16. Kartal, S. N., Terzi, E., Kose, C., Hofmeyr, J., Imamura, Y. (2011). Efficacy of tar oil recovered during slow pyrolysis of macadamia nut shells. International Biodeterioration & Biodegradation, 65(2), 369–373. DOI 10.1016/j.ibiod.2010.08.011. [Google Scholar] [CrossRef]
17. Oramahi, H. A., Yoshimura, T., Diba, F., Setyawati, D., Nurhaida et al. (2018). Antifungal and antitermitic activities of wood vinegar from oil palm trunk. Journal of Wood Science, 64(3), 311–317. DOI 10.1007/s10086-018-1703-2. [Google Scholar] [CrossRef]
18. Pimenta, A. S., Fasciotti, M., Monteiro, T. V. C., Lima, K. M. G. (2018). Chemical composition of pyroligneous acid obtained from eucalyptus GG100 clone. Molecules, 23(2), 426. DOI 10.3390/molecules23020426. [Google Scholar] [CrossRef]
19. Mathew, S., Zakaria, Z. A. (2015). Pyroligneous acid—The smoky acidic liquid from plant biomass. Applied Microbiology and Biotechnology, 99(2), 611–622. DOI 10.1007/s00253-014-6242-1. [Google Scholar] [CrossRef]
20. Theapparat, Y., Chandumpai, A., Leelasuphakul, W., Laemsak, N. (2015). Pyroligneous acids from carbonisation of wood and bamboo: their components and antifungal activity. Journal of Tropical Forest Science, 27(4), 517–526. [Google Scholar]
21. Garcı̀a-Pèrez, M., Chaala, A., Roy, C. (2002). Vacuum pyrolysis of sugarcane bagasse. Journal of Analytical and Applied Pyrolysis, 65(2), 111–136. DOI 10.1016/S0165-2370(01)00184-X. [Google Scholar] [CrossRef]
22. Katyal, S., Thambimuthu, K., Valix, M. (2003). Carbonisation of bagasse in a fixed bed reactor: Influence of process variables on char yield and characteristics. Renewable Energy, 28(5), 713–725. DOI 10.1016/S0960-1481(02)00112-X. [Google Scholar] [CrossRef]
23. Varma, A. K., Mondal, P. (2017). Pyrolysis of sugarcane bagasse in semi batch reactor: Effects of process parameters on product yields and characterization of products. Industrial Crops and Products, 95, 704–717. DOI 10.1016/j.indcrop.2016.11.039. [Google Scholar] [CrossRef]
24. Demirbas, A. (2007). The influence of temperature on the yields of compounds existing in bio-oils obtained from biomass samples via pyrolysis. Fuel Processing Technology, 88(6), 591–597. DOI 10.1016/j.fuproc.2007.01.010. [Google Scholar] [CrossRef]
25. ISO Central Secretary (2015). Solid biofuels—determination of moisture content—oven dry method—part 3: Moisture in general analysis sample. Standard ISO 18134-3:2015, International Organization for Standardization, Geneva, CH. [Google Scholar]
26. ISO Central Secretary (2005). Appliances, solid fuels and firelighters for barbecuing—part 2: Barbecue charcoal and barbecue charcoal briquettes—requirements and test methods. Standard ISO 1860-2:2005, International Organization for Standardization, Geneva, CH. [Google Scholar]
27. ISO Central Secretary (2015). Solid biofuels—determination of ash content. Standard ISO 18122:2015, International Organization for Standardization, Geneva, CH. [Google Scholar]
28. ISO Central Secretary (2015). Solid biofuels—Determination of the content of volatile matter. Standard ISO 18123:2015, International Organization for Standardization, Geneva, CH. [Google Scholar]
29. ISO Central Secretary (2017). Solid biofuels—Determination of calorific value. Standard ISO 18125:2017, International Organization for Standardization, Geneva, CH. [Google Scholar]
30. ASTM D5373. (2016). Standard test methods for determination of carbon, hydrogen and nitrogen in analysis samples of coal and carbon in analysis samples of coal and coke. West Conshohocken, PA: ASTM International. [Google Scholar]
31. ISO Central Secretary (2015). Solid biofuels—determination of total content of carbon, hydrogen and nitrogen. Standard ISO 16948:2015, International Organization for Standardization, Geneva, CH. [Google Scholar]
32. Yang, X., Wang, H., Strong, P. J., Xu, S., Liu, S. et al. (2017). Thermal properties of biochars derived from waste biomass generated by agricultural and forestry sectors. Energies, 10(4), 469. DOI 10.3390/en10040469. [Google Scholar] [CrossRef]
33. Gibb, S., Strimmer, K. (2012). MALDIquant: A versatile R package for the analysis of mass spectrometry data. Bioinformatics, 28(17), 2270–2271. DOI 10.1093/bioinformatics/bts447. [Google Scholar] [CrossRef]
34. RStudio Team. (2018). RStudio: Integrated development for R. Boston, MA:: RStudio, Inc. http://www.rstudio.com/. [Google Scholar]
35. Lê Thành, K., Commandré, J. M., Valette, J., Volle, G., Meyer, M. (2015). Detailed identification and quantification of the condensable species released during torrefaction of lignocellulosic biomasses. Fuel Processing Technology, 139, 226–235. DOI 10.1016/j.fuproc.2015.07.001. [Google Scholar] [CrossRef]
36. ASTM E203-08. (2008). Standard test method for water using volumetric Karl Fischer titration. West Conshohocken, PA: ASTM International. [Google Scholar]
37. Arganda-Carreras, I., Kaynig, V., Rueden, C., Eliceiri, K. W., Schindelin, J. et al. (2017). Trainable Weka Segmentation: A machine learning tool for microscopy pixel classification. Bioinformatics, 33(15), 2424–2426. DOI 10.1093/bioinformatics/btx180. [Google Scholar] [CrossRef]
38. R Core Team. (2019). R: A language and environment for statistical computing. Vienna, Austria: R Foundation for Statistical Computing. http://www.r-project.org/index.html. [Google Scholar]
39. Varma, A. K., Mondal, P. (2017). Pyrolysis of sugarcane bagasse in semi batch reactor: effects of process parameters on product yields and characterization of products. Industrial Crops and Products, 95, 704–717. DOI 10.1016/j.indcrop.2016.11.039. [Google Scholar] [CrossRef]
40. Chae, J. S., Kim, S. W., Ohm, T. I. (2020). Combustion characteristics of solid refuse fuels from different waste sources. Journal of Renewable Materials, 8(7), 789–799. DOI 10.32604/jrm.2020.010023. [Google Scholar] [CrossRef]
41. Pereira, B. L. C., Carneiro, A. D. C. O., Carvalho, A. M. M. L., Colodette, J. L., Oliveira, A. C. et al. (2013). Influence of chemical composition of eucalyptus wood on gravimetric yield and charcoal properties. BioResources, 8(3), 4574–4592. DOI 10.15376/biores.8.3.4574-4592. [Google Scholar] [CrossRef]
42. Demirbaş, A., Demirbaş, A. H. (2004). Estimating the calorific values of lignocellulosic fuels. Energy Exploration & Exploitation, 22(2), 135–143. DOI 10.1260/0144598041475198. [Google Scholar] [CrossRef]
43. Aboulkas, A., Hammani, H., El Achaby, M., Bilal, E., Barakat, A. et al. (2017). Valorization of algal waste via pyrolysis in a fixed-bed reactor: Production and characterization of bio-oil and bio-char. Bioresource Technology, 243, 400–408. DOI 10.1016/j.biortech.2017.06.098. [Google Scholar] [CrossRef]
44. Morais, L. C., Maia, A. A. D., Guandique, M. E. G., Rosa, A. H. (2017). Pyrolysis and combustion of sugarcane bagasse. Journal of Thermal Analysis and Calorimetry, 129(3), 1813–1822. DOI 10.1007/s10973-017-6329-x. [Google Scholar] [CrossRef]
45. Crombie, K., Mašek, O., Sohi, S. P., Brownsort, P., Cross, A. (2013). The effect of pyrolysis conditions on biochar stability as determined by three methods. Global Change Biology Bioenergy, 5(2), 122–131. DOI 10.1111/gcbb.12030. [Google Scholar] [CrossRef]
46. Mesa-Perez, J. M., Cortez, L. A. B., Rocha, J. D., Brossard-Perez, L. E., Olivares-Gómez, E. (2005). Unidimensional heat transfer analysis of elephant grass and sugar cane bagasse slow pyrolysis in a fixed bed reactor. Fuel Processing Technology, 86(5), 565–575. DOI 10.1016/j.fuproc.2004.05.014. [Google Scholar] [CrossRef]
47. Demirbas, A. (2007). The influence of temperature on the yields of compounds existing in bio-oils obtained from biomass samples via pyrolysis. Fuel Processing Technology, 88(6), 591–597. DOI 10.1016/j.fuproc.2007.01.010. [Google Scholar] [CrossRef]
48. Islam, M. R., Parveen, M., Haniu, H. (2010). Properties of sugarcane waste-derived bio-oils obtained by fixed-bed fire-tube heating pyrolysis. Bioresource Technology, 101(11), 4162–4168. DOI 10.1016/j.biortech.2009.12.137. [Google Scholar] [CrossRef]
49. Demiral, İ., Atilgan, N. G., Şensöz, S. (2009). Production of biofuel from soft shell of pistachio (Pistacia vera L). Chemical Engineering Communications, 196(1–2), 104–115. DOI 10.1080/00986440802300984. [Google Scholar] [CrossRef]
50. Temiz, A., Alma, M. H., Terziev, N., Palanti, S., Feci, E. (2010). Efficiency of bio-oil against wood destroying organisms. Journal of Biobased Materials and Bioenergy, 4(4), 317–323. DOI 10.1166/jbmb.2010.1092. [Google Scholar] [CrossRef]
51. Bezerra, T. L., Ragauskas, A. J. (2016). A review of sugarcane bagasse for second-generation bioethanol and biopower production. Biofuels, Bioproducts and Biorefining, 10(5), 634–647. DOI 10.1002/bbb.1662. [Google Scholar] [CrossRef]
52. Kartal, S. N., Imamura, Y., Tsuchiya, F., Ohsato, K. (2004). Preliminary evaluation of fungicidal and termiticidal activities of filtrates from biomass slurry fuel production. Bioresource Technology, 95(1), 41–47. DOI 10.1016/j.biortech.2004.02.005. [Google Scholar] [CrossRef]
53. Guo, Y., Wu, K., Huo, X., Xu, X. (2011). Sources, distribution, and toxicity of polycyclic aromatic hydrocarbons. Journal of Environmental Health, 73(9), 22–25. [Google Scholar]
54. The British Standards Institution (2004). Derivatives from coal pyrolysis—Coal tar based oils: Creosotes—Specifications and test methods. Standard BS EN 13991:2004, The British Standards Institution, London, UK [Google Scholar]
55. Cordella, M., Torri, C., Adamiano, A., Fabbri, D., Barontini, F. et al. (2012). Bio-oils from biomass slow pyrolysis: a chemical and toxicological screening. Journal of Hazardous Materials, 231, 26–35. DOI 10.1016/j.jhazmat.2012.06.030. [Google Scholar] [CrossRef]
56. Li, N., Yi, W., Li, Z., Wang, L., Li, Y. et al. (2020). Pyrolysis of rice husk in a fluidized bed reactor: Evaluate the characteristics of fractional bio-oil and particulate emission of carbonaceous aerosol (CA). Journal of Renewable Materials, 8(3), 329–346. DOI 10.32604/jrm.2020.08618. [Google Scholar] [CrossRef]
57. Mohan, D., Shi, J., Nicholas, D. D., Pittman, C. U., Steele, P. H. et al. (2008). Fungicidal values of bio-oils and their lignin-rich fractions obtained from wood/bark fast pyrolysis. Chemosphere, 71(3), 456–465. DOI 10.1016/j.chemosphere.2007.10.049. [Google Scholar] [CrossRef]
58. Mourant, D., Yang, D. Q., Lu, X., Roy, C. (2005). Anti-fungal properties of the pyroligneous liquors from the pyrolysis of softwood bark. Wood and Fiber Science, 37(3), 542–548. [Google Scholar]
59. Yasuhara, A., Sugiura, G. (1987). Volatile compounds in pyroligneous liquids from karamatsu and chishima-sasa. Agricultural and Biological Chemistry, 51(11), 3049–3060. DOI 10.1271/bbb1961.51.3049. [Google Scholar] [CrossRef]
60. Oramahi, H. A., Yoshimura, T. (2013). Antifungal and antitermitic activities of wood vinegar from Vitex pubescens Vahl. Journal of Wood Science, 59(4), 344–350. DOI 10.1007/s10086-013-1340-8. [Google Scholar] [CrossRef]
61. Mattos, C., Veloso, M. C. C., Romeiro, G. A., Folly, E. (2019). Biocidal applications trends of bio-oils from pyrolysis: Characterization of several conditions and biomass, a review. Journal of Analytical and Applied Pyrolysis, 139, 1–12. DOI 10.1016/j.jaap.2018.12.029. [Google Scholar] [CrossRef]
62. Wititsiri, S. (2011). Production of wood vinegars from coconut shells and additional materials for control of termite workers, Odontotermes sp. and striped mealy bugs, Ferrisia virgata. Songklanakarin Journal of Science and Technology, 33(3), 349–354. [Google Scholar]
63. Yatagai, M., Nishimoto, M., Hori, K., Ohira, T., Shibata, A. (2002). Termiticidal activity of wood vinegar, its components and their homologues. Journal of Wood Science, 48(4), 338–342. DOI 10.1007/BF00831357. [Google Scholar] [CrossRef]
64. Lourençon, T. V., Mattos, B. D., Cademartori, P. H. G., Magalhães, W. L. E. (2016). Bio-oil from a fast pyrolysis pilot plant as antifungal and hydrophobic agent for wood preservation. Journal of Analytical and Applied Pyrolysis, 122, 1–6. DOI 10.1016/j.jaap.2016.11.004. [Google Scholar] [CrossRef]
65. Kartal, S. N., Hwang, W. J., Imamura, Y., Sekine, Y. (2006). Effect of essential oil compounds and plant extracts on decay and termite resistance of wood. Holz als Roh-und Werkstoff, 64(6), 455–461. DOI 10.1007/s00107-006-0098-8. [Google Scholar] [CrossRef]
66. Pánek, M., Reinprecht, L., Hulla, M. (2014). Ten essential oils for beech wood protection—Efficacy against wood-destroying fungi and moulds, and effect on wood discoloration. BioResources, 9(3), 5588–5603. DOI 10.15376/biores.9.3.5588-5603.
67. Xie, Y., Wang, Z., Huang, Q., Zhang, D. (2017). Antifungal activity of several essential oils and major components against wood-rot fungi. Industrial Crops and Products, 108, 278–285. DOI 10.1016/j.indcrop.2017.06.041.
68. Bahmani, M., Schmidt, O. (2018). Plant essential oils for environment-friendly protection of wood objects against fungi. Maderas. Ciencia y Tecnología, 20(3), 325–332. DOI 10.4067/S0718-221X2018005003301. [Google Scholar] [CrossRef]
69. Hu, J., Thevenon, M. F., Palanti, S., Tondi, G. (2017). Tannin-caprolactam and Tannin-PEG formulations as outdoor wood preservatives: Biological properties. Annals of Forest Science, 74(1), 18. DOI 10.1007/s13595-016-0606-x. [Google Scholar] [CrossRef]
70. Silveira, A. G. D., Santini, E. J., Kulczynski, S. M., Trevisan, R., Wastowski, A. D. et al. (2017). Tannic extract potential as natural wood preservative of Acacia mearnsii. Academia Brasileira de Ciências, 89(4), 3031–3038. DOI 10.1590/0001-3765201720170485. [Google Scholar] [CrossRef]
71. Candelier, K., Thevenon, M. F., Petrissans, A., Dumarcay, S., Gerardin, P. et al. (2016). Control of wood thermal treatment and its effects on decay resistance: A review. Annals of Forest Science, 73(3), 571–583. DOI 10.1007/s13595-016-0541-x. [Google Scholar] [CrossRef]
72. Gérardin, P. (2016). New alternatives for wood preservation based on thermal and chemical modification of wood—A review. Annals of Forest Science, 73(3), 559–570. DOI 10.1007/s13595-015-0531-4.
73. Salman, S., Thévenon, M. F., Pétrissans, A., Dumarçay, S., Candelier, K. et al. (2017). Improvement of the durability of heat-treated wood against termites. Maderas. Ciencia y Tecnología, 19(3), 317–328. DOI 10.4067/S0718-221X2017005000027. [Google Scholar] [CrossRef]
74. Bridgwater, A. V., Carson, P., Coulson, M. (2007). A comparison of fast and slow pyrolysis liquids from mallee. International Journal of Global Energy Issues, 27(2), 204–216. DOI 10.1504/IJGEI.2007.013655. [Google Scholar] [CrossRef]